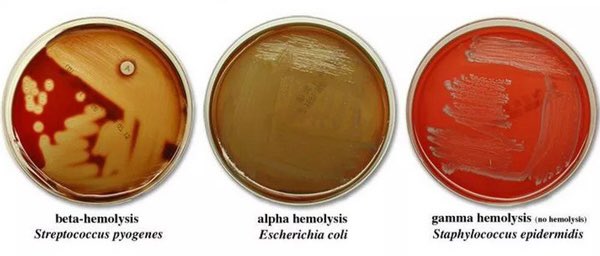

شنو بنسوي في لاب المايكرو؟
بنتعامل مع جميع أنواع العينات عشان نشوف شنو السبب في الآلآم وتعب المريض، هل باكتيريا مثلاً؟ أي باكتيريا بالضبط؟
عشان بنحدد له بعدها نوع المضاد الحيوي المناسب له لِقتل البكتيريا
مِشاكل في الكلى؟ مشاكل في الإنجاب؟
أشياء كثيره بنعرفها في هاللاب 🧫
بنتعامل مع جميع أنواع العينات عشان نشوف شنو السبب في الآلآم وتعب المريض، هل باكتيريا مثلاً؟ أي باكتيريا بالضبط؟
عشان بنحدد له بعدها نوع المضاد الحيوي المناسب له لِقتل البكتيريا
مِشاكل في الكلى؟ مشاكل في الإنجاب؟
أشياء كثيره بنعرفها في هاللاب 🧫
طَبعاً أنا بتكلم عن لاب المايكرو اللي أنا دَخلته مدري عن تقسيم المستشفيات الثانيه يعني 💁♀️
لاب المايكرو كان مِقسم إلى ٤ أقسام
general, routine, stat, sense
لاب المايكرو كان مِقسم إلى ٤ أقسام
general, routine, stat, sense
ثريد اليوم بتكلم فيه عن بِنش الجنرال
طَبعاً في لاب المايكرو حرفياً بتجيكم كل أنواع العَينات
فيه urine, stool, swab
في بنش الجِنرال راح نستقبل الswab بأنواعها
يعني urine, stool, blood بيروحون عند الجهات الثانية
طَبعاً في لاب المايكرو حرفياً بتجيكم كل أنواع العَينات
فيه urine, stool, swab
في بنش الجِنرال راح نستقبل الswab بأنواعها
يعني urine, stool, blood بيروحون عند الجهات الثانية
مهم نكون عارفين أنواع الميديا اللي نستخدمها في اللاب وكل ميديا لِ شنو نستخدمها وليش نستخدم الميديا من الأساس؟
فِكرة الميديا إنه بيكون فيها مواد تتغذى عليها الباكتيريا عشان تنمو وتتكاثر وبعد مانحطها في incubation لمدة يوم مثلاً بنجي ونشوف الباكتيريا وبنشوف التغيير اللي صار في الميديا وهالشيء بيساعدني في تحديد نوع الباكتيريا
الميديا فيه منها أنواع، مب كل الباكتيريا بتنمو على نوع واحد من الميديا
بتكلم عن أنواع الميديا بِشكل سريع
بتكلم عن أنواع الميديا بِشكل سريع
3- Selective and differential :
مثل : MacConky agar
سميناها selective لأنها تحتوي على crystal violet + bile salt اللي بيثبطون نمو gram-positive bacteria ويخلون gram-negative bacteria هي اللي تنمو بس
مثل : MacConky agar
سميناها selective لأنها تحتوي على crystal violet + bile salt اللي بيثبطون نمو gram-positive bacteria ويخلون gram-negative bacteria هي اللي تنمو بس
فيه بعد كِنا نستخدم brain- heat infusion “ BHI “
هَذي الميديا فيها مواد تحفز نمو الباكتيريا الدلوعه مثل
streptococci, pneumococci and meningococci
طبعاً مانستخدمها مع كل العينات ليش؟
هَذي الميديا فيها مواد تحفز نمو الباكتيريا الدلوعه مثل
streptococci, pneumococci and meningococci
طبعاً مانستخدمها مع كل العينات ليش؟
طَبعاً فيه أنواع أكثر للميديا بس نكتفي بِهذا القدر عشان أكمل الثريد
الحين بعد ماعرفنا كل ميديا وشنو البرسنبل حقها وشنو ينزرع عليها
الحين بعد ماعرفنا كل ميديا وشنو البرسنبل حقها وشنو ينزرع عليها
بَعض العينات بتحتاج تعامل خاص مِثل sputum
لازم أول ماتجينا نشوف هل هي فِعلاً sputum أو ممكن انها تكون saliva
باخذ العينة وبفردها على سلايد وبحطها على heater عشان تثبت بعدها بصبغها بصبغه وبشوفها تحت المايكروسكوب
لازم أول ماتجينا نشوف هل هي فِعلاً sputum أو ممكن انها تكون saliva
باخذ العينة وبفردها على سلايد وبحطها على heater عشان تثبت بعدها بصبغها بصبغه وبشوفها تحت المايكروسكوب
المفترض إن عدد epithelial cell يكون تحت ال ١٠ وpus cell يكون ٢٥ وفوق
لو كان epithelial cell أكثر من ١٠ معناها ان هالعينةsaliva مو sputum
لو كان epithelial cell أكثر من ١٠ معناها ان هالعينةsaliva مو sputum
عَينات الشعر والأظافر بنكون شاكيين إنه فيه fungal infection فَ بنحطهم في KOH عشان تتوضح لي الرؤية تحت المايكروسكوب
وبِما ان اني أبي أزرع Fungal بستخدم SDA media
وبِما ان اني أبي أزرع Fungal بستخدم SDA media
- Acinetobacter
- CRE
بنزرعهم على macConky بِما إنهم gram-negative bacteria
- CRE
بنزرعهم على macConky بِما إنهم gram-negative bacteria
وَبس والله أتمنى يكون شرحي واضح ومفهوم
تكملة الأقسام الثانيه من المايكرو إن شاء الله مع الأيام الجاية وبالتوفيق ❤️
تكملة الأقسام الثانيه من المايكرو إن شاء الله مع الأيام الجاية وبالتوفيق ❤️
جاري تحميل الاقتراحات...